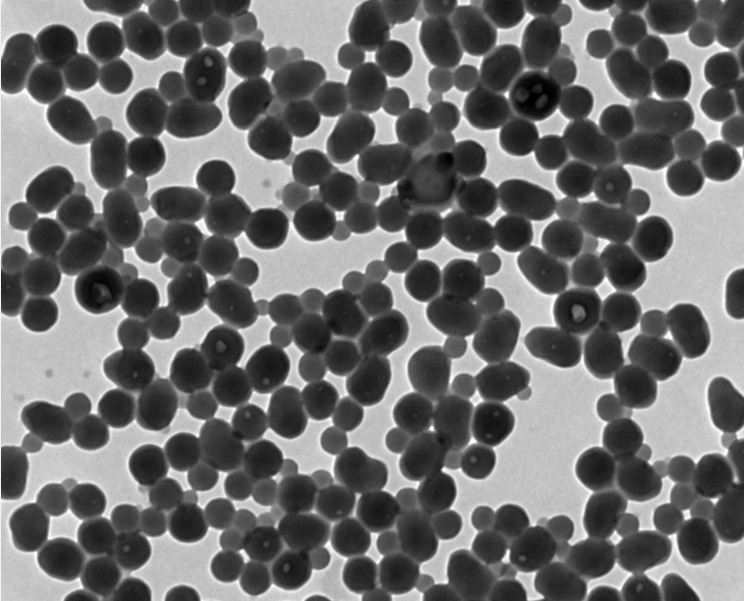

单分散荧光纳米粒子制备及其FRET性能研究毕业论文
2020-04-18 20:00:59
摘 要
近年来,荧光材料因为在成像及传感器、标记等领域应用的潜力而引发各界关注。通过改变两种染料的混合比例,可以调节荧光共振能量转移(FRET)介导的发射信号,使纳米粒子在单一波长激发下呈现多种颜色。
多色荧光纳米材料在单一波长激发下表现出多种可分辨的发射信号,由于它们可以将荧光测量的复杂性降到最低,从而显著简化了仪器的要求,同时允许同时激发实验中涉及的所有荧光团,因此特别具有吸引力。
本文首先对荧光纳米粒子进行了介绍,并运用细乳液聚合的方法,利用苯乙烯、丙烯腈和功能单体等,对不同的荧光染料(水性或油性)进行包覆制备纳米级级单分散荧光纳米粒子,同时并进一步研究树脂内不同荧光染料间的荧光共振能量转移(FRET)性能,筛选荧光染料,优化染料配比,制备具有大的斯托克斯位移(Stokes shift)的荧光纳米粒子。研究分析温度、时间以及染料用量对荧光纳米粒子性能的影响。实验得出荧光效果最佳的温度为80℃,引发剂用量占单体总量的2%,得到粒径小,分布均匀的纳米粒子,粒径范围是50~500nm,染料配比为红黄1:0,红黄1:1,红黄2:1,红黄3:1和红黄0:1。
关键词:单分散 荧光 纳米粒子 荧光共振能量转移
Preparation of monodisperse fluorescent nanoparticles and FRET performance study
Abstract
Recently,many people have attention to all walks of life caused by changing the mix proportion of dyes to strengthen the fluorescence resonance energy transfer (FRET) mediated emission signal, make the nanoparticles under a single wavelength excitation presents a variety of color。
Multicolor fluorescence inspired by showing a variety of nano materials in a single wavelength can distinguish emission signals, since they can minimize the complexity of fluorescence measurement, thus significantly simplify the instrument requirements, while at the same time allowing invoke all experiments involved in the fluorophore, so especially attractive。
This paper on the fluorescent nanoparticles are introduced, and applied the method of emulsion polymerization using styrene, acrylonitrile and functional monomer, etc., for different fluorescent dyes (aqueous or oily) preparation slopes monodisperse nanoparticles coated fluorescent nanoparticles, and further research resin of different fluorescent dyes fluorescence resonance energy transfer (FRET) performance, screening and optimizing the ratio of dye, fluorescent dye preparation with large Stokes shift fluorescent nanoparticles (Stokes shift).The optimum potimum ploymerization conditions were determined by changing the temperature,time and dye ratio.Nanoparticles with small particle size and good monodispersity can be obtained when the amount of initiator is 2% of the monomer mass, the particle size range is 50~500nm, and the dye ratio is 1:0 red yellow, 1:1 red yellow, 2:1 red yellow, 3:1 red yellow and 0:1 red yellow
Key Words: Monodisperse; fluorescence; nanoparticles; fluorescence resonance energy transfer
目 录
摘 要 I
Abstract II
第一章 文献综述 1
1.1单分散荧光纳米粒子的性质 1
1.2单分散纳米颗粒的制备方法 1
1.2.1细乳液聚合法 1
1.2.2水热法 3
1.2.3均匀沉淀法 4
1.3斯托克斯位移的概述 5
1.4荧光共振能量转移(FRET) 5
1.4.1FRET概述 5
1.4.2检测FRET的方法 6
1.5本课题设想 6
第二章 实验部分 8
2.1实验材料 8
2.2实验药品 8
2.3实验仪器 9
2.4实验过程 9
2.4.1染料配比 9
2.4.2实验过程 10
2.5FRET性能测试 11
第三章 结果与讨论 12
3.1温度对荧光纳米粒子制备的影响 12
3.2单体与引发剂对荧光纳米粒子制备的影响 12
3.3染料比例对荧光效果的影响 13
3.4不同荧光染料在乳胶粒树脂类的FRET现象 15
第四章 实验结论与展望 17
4.1实验结论 17
4.2展望 17
参考文献 18
致 谢 21
第一章 文献综述
1.1单分散荧光纳米粒子的性质
单分散是纳米级乳液颗粒分散的一种状态(均匀、光滑、形状大小相同),由于处于单分散状态的乳液各项性能较好,因此单分散粒子应用面较广。也可以为一些设备检测其他粒子检测结果进行验证,同时,单分散粒子应用面较广,可用于建筑材料,纸张着色,纺织品着色,警示标识,交通等诸多领域,相比较于多分散粒子的性能要更胜一筹[1]。
单分散的乳胶颗粒在催化剂 、光散射标准物还有生物判断等各领域有着非常多的应用[2]。因为在单分散乳胶颗粒上可以产生一种二维或者三维的有秩序的排列布阵,所以经常用他制造胶水、无机或有机多孔、中空材料,得到的产物在生物学、医学、光学等领域都将有着无穷的应用[3-4]。
以上是毕业论文大纲或资料介绍,该课题完整毕业论文、开题报告、任务书、程序设计、图纸设计等资料请添加微信获取,微信号:bysjorg。
相关图片展示: